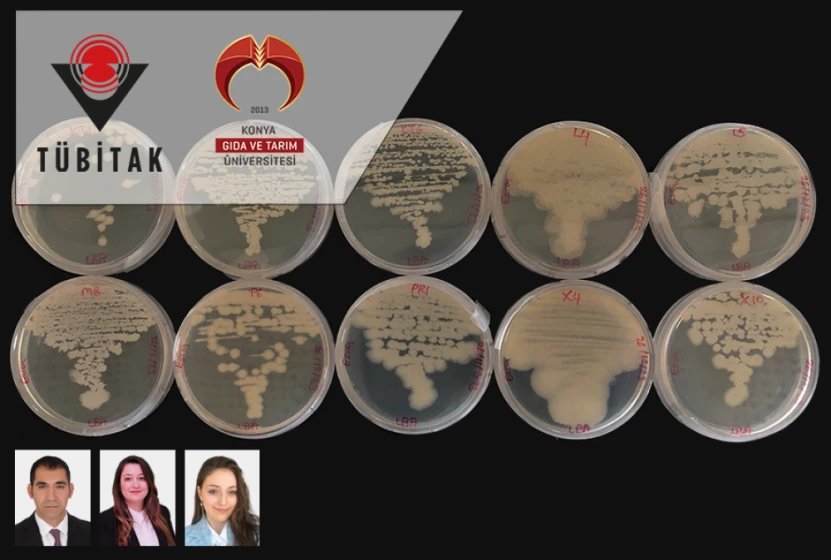

KGTÜ ve Konya Şeker İş Birliğiyle Altınekin’de Çiftçi Buluşması Gerçekleştirildi
2026-01-22 13:43:47
Psikoloji Bölümümüzde FEDEK Akreditasyon Değerlendirme Ziyareti Başarıyla Tamamlandı
2026-01-22 08:20:53
2025-2026 Güz Dönemi IMB4001 İç Mimari Proje-V Final Jürisi Başarıyla Tamamlandı
2026-01-19 11:03:39